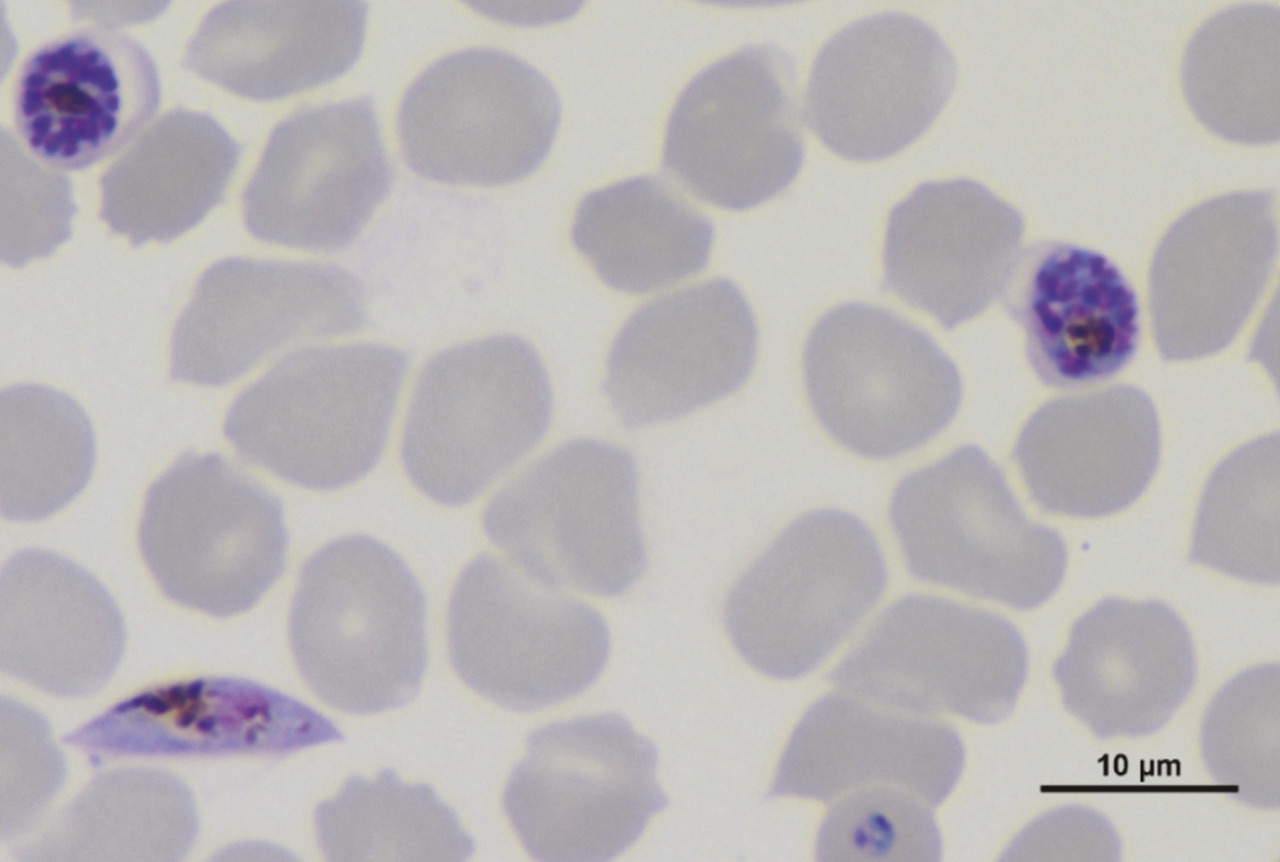
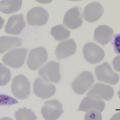

Paludisme. L’apparition en Asie de souches résistantes à l’artémisinine est une menace considérable pour l’Afrique.
Le paludisme (ou malaria) est une parasitose des régions tropicales et subtropicales causée par la prolifération, à l’intérieur des globules rouges, du parasite Plasmodium (v. figure) transmis par la piqûre d’un moustique du genre Anopheles. Avec 216 millions de cas et 445 000 décès en 2016, le paludisme est la troisième cause de mortalité due à une maladie infectieuse, après la tuberculose et le sida.1 Depuis 2000, le nombre de nouveaux cas et de décès a été réduit de 60 % grâce à l’action combinée de mesures préventives comme la distribution massive de moustiquaires imprégnées d’insecticide, l’utilisation de tests de diagnostic rapide permettant une meilleure prise en charge des cas, et à l’emploi à visée curative des combinaisons thérapeutiques à base d’un dérivé d’artémisinine (artemisinin-based combination therapies [ACT]). Ces progrès significatifs dans la lutte contre le paludisme sont cependant menacés par l’émergence et la propagation rapide de parasites résistants aux ACT.1
Artémisinine et ACT
L’artémisinine (v. encadré) isolée de la plante Artemisia annua et ses dérivés semi-synthétiques (artéméther, artésunate et dihydroartémisinine), regroupés sous le terme « artémisinines » lato sensu, sont actuellement les médicaments antipaludiques les plus efficaces, capables d’éliminer les parasites (y compris ceux résistants à d’autres molécules comme la chloroquine) plus rapidement que tous les autres antipaludiques. Cependant, les propriétés pharmacocinétiques de ces molécules (demi-vie plasmatique inférieure à 2 heures) ont conduit l’Organisation mondiale de la santé (OMS) à préconiser l’utilisation des artémisinines en combinaison avec un autre médicament antipaludique. Ces molécules partenaires ont des modes d’action, des cibles thérapeutiques et des caractéristiques pharmacoci- nétiques différents de ceux des arté- misinines avec des demi-vies plus longues (de quelques jours à quelques semaines) permettant l’élimination des parasites résiduels ayant échappé à l’action des artémisinines. Les ACT sont recommandées depuis 2001 par l’OMS dans le traitement de première intention du paludisme non compliqué à Plasmodium falciparum.1 Six ACT sont actuellement utilisées : artéméther-luméfantrine, artésunate-amodiaquine, artésunate-méfloquine, artésunate-sulfadoxine-pyriméthamine, dihydroartémisinine-pipéraquine et la combinaison artésunate-pyronaridine est à l’étude en vue d’une recommandation par l’OMS.1 (v. tableau). Malheureusement les ACT de qualité médiocre et/ou contrefaites sont très répandues, notamment en Asie avec jusqu’à 50 % d’artésunate contrefait. En Afrique, les ACT vendues sans contrôle de leur qualité sont omniprésentes ; dans 7 pays audités en 2014, entre 32 et 89 % des ACT utilisées n’atteignaient pas les normes requises.2 De manière générale, l’utilisation de médicaments de mauvaise qualité, la faible observance des traitements, ainsi que l’utilisation de monothérapies sont les principaux facteurs favorisant l’émergence de pathogènes résistants. En 2014, l’Angola, le Cap-Vert, la Colombie, la Guinée équatoriale, la Gambie, Sao Tomé-et-Principe, la Somalie et le Swaziland permettaient encore l’utilisation des artémisinines en monothérapie, malgré l’interdiction de l’OMS.3
Résistance aux artémisinines
La résistance aux artémisinines mise en évidence en 2008 à la frontière Thaïlande-Cambodge aurait probablement émergé dès 2001.4 Associée à une mutation du gène pfk13,5 elle se différencie des résistances aux autres antipaludiques par un mécanisme original « d’endormis- sement », appelé dormance ou quiescence. Ces parasites deviennent insensibles aux artémisinines pendant toute la durée du traitement, puis se « réveillent » pour reprendre leur prolifération, une fois le traitement éliminé. D’un point de vue clinique, cette résistance se manifeste par un retard de clairance parasitaire, cependant l’ACT reste efficace tant qu’il n’y a pas de résistance à la molécule partenaire. Toutefois, en raison même des propriétés pharmacocinétiques différentes des deux principes actifs, notamment la très courte demi-vie des dérivés de l’artémisinine, la résistance aux artémisinines favorise la sélection de parasites également résistants à la molécule partenaire, ce qui risque de conduire à une véritable impasse thérapeutique.3
Situation actuelle
Malgré la forte prévalence des parasites résistants aux artémisinines en Asie et les retards de clairance parasitaire rapportés, les ACT res- tent encore efficaces pour traiter la très grande majorité des cas de paludisme. Cependant, deux cas d’échec clinique total à l’artésunate (qualifié certifiée) administré par voie veineuse (recommandation du traitement du paludisme sévère) ont été rapportés en 2018 ; l’un des patients est décédé dans les 24 heures suivant le début du traitement. Le second patient a pu être guéri à J10, après un traitement intraveineux par artésunate et quinine complété par atovaquone-proguanil et deux transfusions sanguines.6
Aujourd’hui, la résistance aux artémisinines est limitée à l’Asie du Sud-Est.1, 4 Dans certaines de ces régions, plus de 95 % des parasites sont résistants aux artémisinines. Cette situation résulte non seulement de la propagation mais aussi des émergences indépendantes de parasites résistants.3 Une augmen- tation des cas de résistances à la fois aux artémisinines et aux antipaludiques partenaires a été observée ces dernières années, notamment pour la combinaison dihydroarté- misinine-pipéraquine. Cette double résistance a émergé moins de 5 ans après l’introduction de cette ACT dans l’arsenal thérapeutique. Des taux d’échecs cliniques supérieurs à 10 % sont signalés pour 5 ACT au Cambodge, pour 2 ACT en Thaïlande, au Laos et au Vietnam, et pour 1 ACT au Myanmar et dans la zone frontalière Myanmar-Chine-Inde.4 Lorsque le taux d’échecs cliniques après traitement par une ACT est supérieur à 10 % dans une région, l’OMS recommande alors son remplacement par une autre ACT dont l’efficacité sera évaluée tous les 2 ans afin d’adapter le plus rapidement possible les politiques de santé sur le terrain.1, 4
L’utilisation cyclique des ACT est également envisagée en raison de la restauration possible dans une population parasitaire de la sensibilité à un antipaludique donné après l’arrêt de son utilisation. Cette sensibilité retrouvée n’est pas systématique, comme le montre le cas du Venezuela où les parasites sont restés résistants à la chloroquine plus de 15 ans après l’arrêt de son utilisation. Des ACT associant trois principes actifs sont en étude clinique tels que la combinaison dihydroartémisinine-pipéraquine- méfloquine. Cette nouvelle combinaison repose sur la sensibilité à la méfloquine des parasites résistants à la pipéraquine et inversement.3 Cependant, la présence de parasites résistants aux artémisinines et à la pipéraquine, et portant également des marqueurs de la résistance à la méfloquine, ont été observés sur le terrain moins de 1 an après l’introduction de cette nouvelle combinaison.7
Risques de résistance croisée et molécules en développement
Dix-neuf nouvelles molécules antipaludiques ou nouvelles formulations de composés déjà utilisés sont actuellement en développement (Medicines for Malaria Venture* [MMV] portfolio 2018). L’artéfénomel et l’artérolane font partie des composés les plus prometteurs, développés en combinaison respectivement avec la ferroquine et la pipéraquine. Les activités antipaludiques de l’artéfénomel et l’artérolane reposent sur la présence, dans leur structure chimique, d’un endoperoxyde, comme pour l’artémisinine (fig. 2). Même si les premières études cliniques sont encourageantes, les similitudes chimiques entre l’artémisinine et ces nouveaux antipaludiques, et leur même mode d’action associé, pourraient être responsables d’un phénomène de résistance croisée. En effet, les parasites résistants aux artémisinines semblent avoir une sensibilité diminuée à l’artérolane in vitro. Des expériences réalisées en laboratoire ont également montré qu’il est possible de sélectionner des parasites résistants aux artémisinines par des expositions répétées avec différents composés comportant cette même fonction endoperoxyde (fig. 2).3 Le portefeuille de molécules antipaludiques, en cours d’étude, fondé sur de nouvelles structures chimiques et de nouveaux mécanismes d’action, n’offre pas à l’heure actuelle de candidats médicaments proches de la mise sur le marché. Il n’y a donc pas à court et moyen terme d’alternative aux artémisinines, laissant craindre une impasse thérapeutique.
Risques d’émergence et/ou de propagation de la résistance aux artémisinines en dehors de l’Asie
Toutes les résistances aux médicaments antipaludiques ont émergé en Asie du Sud-Est avant de se propager ou d’émerger dans les autres régions touchées par le paludisme. Ce fut le cas pour la résistance à la chloroquine, apparue à la fin des années 1950 en Asie et dont la propagation en Afrique et l’émergence en Amérique du Sud, 20 ans plus tard, ont entraîné une augmentation consi- dérable de la mortalité due au paludisme. En Asie, deux espèces de moustiques, Anopheles dirus et Anopheles minimus, sont responsables de la transmission à l’homme du parasite Plasmodium falciparum. En 2016, il a été démontré que les parasites résistants aux artémisinines présents en Asie pouvaient également être transmis par le moustique Anopheles gambiae, espèce responsable de la transmission du paludisme en Afrique.8
L’utilisation des artémisinines, d’abord en monothérapie dans les années 1980 en Chine, puis de manière progressive en combinaison dans les années 1990 en Asie du Sud-Est, a conduit à l’émergence de la résistance dès 2001. En Amérique du Sud et en Afrique, où les ACT ont été recommandées dans l’arsenal thérapeutique antipaludique en 2001, la surveillance de l’émergence de la résistance aux artémisinines est au cœur des préoccupations des organismes de santé et des gouvernements. L’apparition d’une telle résistance en Afrique, où se concentrent 90 % des décès dus au paludisme, aurait un impact dévastateur tant sur la mortalité que sur la morbidité et ses répercussions économiques.
https://www.mmv.org ou https://bit.ly/2wt5sCL
L’artémisinine est extraite de l’armoise Artemisia annua (Asteraceae) ou qinghao en chinois. Cette plante est utilisée en médecine traditionnelle depuis 2 000 ans pour le traitement des fièvres. La découverte de l’artémisinine par la Pr Youyou Tu a été récompensée par le prix Nobel de médecine en 2015*. La fonction endoperoxyde retrouvée dans la structure chimique de l’artémisinine et de ses dérivés est visualisée en rose (fig.2).
* Pour en savoir plus
V. l’article paru dans La Revue du praticien en janvier 2016 : Bouchaud O. Artémisinine et ivermectine : le Nobel qui récompense des millions de morts évitées. Rev Prat 2016;66(1):7-9.
1. WHO. World malaria report 2017.
2. ACTwatch Group, Newton PN, Hanson K, Goodman C. Do anti-malarials in Africa meet quality standards? The market penetration of non quality-assured artemisinin combination therapy in eight African countries. Malar J 2017;16:204.
3. Ouji M, Augereau JM, Paloque L, Benoit-vical F. Plasmodium falciparum resistance to artemisinin-based combination therapies : A sword of Damocles in the path toward malaria elimination. Parasite 2018;25:24.
4. WHO. Artemisinin and artemisinin-based combination therapy resistance. 2017. WHO/HTM/GMP/2017.9.
5. Ariey F, Witkowski B, Amaratunga C, et al. A molecular marker of artemisinin-resistant Plasmodium falciparum malaria. Nature 2014;505:50-5.
6. Phyo AP, Win KK, Thu AM, et al. Poor response to artesunate treatment in two patients with severe malaria on the Thai-Myanmar border. Malar J 2018;17:30.
7. Rossi G, De Smet M, Khim N, Kindermans JM, Menard D. Emergence of Plasmodium falciparum triple mutant in Cambodia. Lancet Infect Dis 2017;17:1233.
8. St Laurent B, Miller B, Burton TA, et al. Artemisinin- resistant Plasmodium falciparum clinical isolates can infect diverse mosquito vectors of Southeast Asia and Africa. Nat Commun 2015;6:8614.

 Encadrés
Encadrés